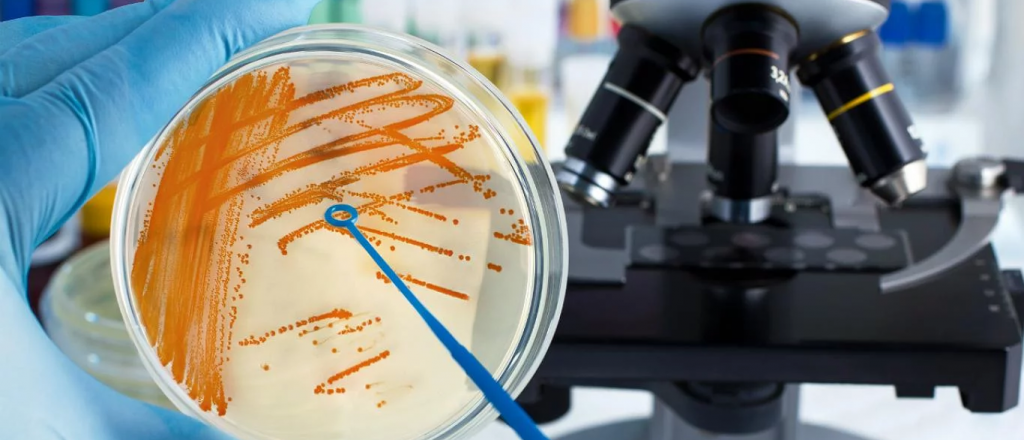
Un beb&eacute; de R&iacute;o Negro es la sexta v&iacute;ctima fatal  por estreptococo

El hecho fue confirmado por el Ministerio de Salud de la provincia.
Un bebé de Río Negro es la sexta víctima fatal por estreptococo
Un niño de 20 meses falleció en la ciudad rionegrina de Viedma y ya son seis las personas muertas por la bacteria estreptococo.
Así lo confirmó este miércoles Mercedes Ibero, secretaria de Relaciones Institucionales del Ministerio de Salud de Río Negro, quien comentó que el deceso del niño se produjo el pasado 3 de septiembre, según consignó la agencia Noticias Argentinas.
Alerta estreptococo: habló el jefe de Toxicología de Mendoza
"Ya tenía una patología previa, estaba con neumonía y se sobreinfectó", explicó Ibero. El bebé no se "había dado a conocer" porque faltaba la confirmación de Salud de Río Negro, según Perfil.